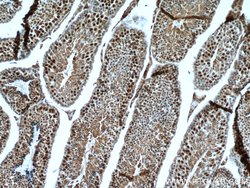
RTCD1 Rabbit anti-Human, Mouse, Rat, Polyclonal, Proteintech:Antibodies:Primary

missing translation for 'onlineSavingsMsg'
Learn More
Learn More
RTCD1 Rabbit anti-Human, Mouse, Rat, Polyclonal, Proteintech
Rabbit Polyclonal Antibody
£135.00 - £349.00
Specifications
| Antigen | RTCD1 |
|---|---|
| Concentration | 0.13 mg/mL |
| Applications | Immunohistochemistry (Paraffin), Western Blot |
| Classification | Polyclonal |
| Conjugate | Unconjugated |
| Product Code | Brand | Quantity | Price | Quantity & Availability | |||||
|---|---|---|---|---|---|---|---|---|---|
| Product Code | Brand | Quantity | Price | Quantity & Availability | |||||
|
16875424
|
Proteintech
15996-1-AP-20UL |
20 μL |
£135.00
20µL |
Please sign in to purchase this item. Need a web account? Register with us today! | |||||
|
16865424
|
Proteintech
15996-1-AP-150UL |
150 μL |
£349.00
150µL |
Please sign in to purchase this item. Need a web account? Register with us today! | |||||
Description
RTCD1 catalyzes the conversion of 3′-phosphate to a 2′, 3′-cyclic phosphodiester at the end of RNA. The mechanism of action of the enzyme occurs in 3 steps: (A) adenylation of the enzyme by ATP; (B) the enzyme acts on RNA-N3′P to produce RNA-N3′PP5′A; (C) a non catalytic nucleophilic attack by the adjacent 2′hydroxyl on the phosphorus in the diester linkage to produce the cyclic end product. The biological role of this enzyme is unknown but it is likely to function in some aspects of cellular RNA processing. There are two named isoforms.Specifications
| RTCD1 | |
| Immunohistochemistry (Paraffin), Western Blot | |
| Unconjugated | |
| Rabbit | |
| Human, Mouse, Rat | |
| O00442, Q9D7H3 | |
| 295395, 66368, 8634 | |
| RTCD1 Fusion Protein Ag8904 | |
| Primary | |
| -20°C | |
| RTCA |
| 0.13 mg/mL | |
| Polyclonal | |
| Liquid | |
| RUO | |
| PBS with 50% glycerol and 0.02% sodium azide; pH 7.3 | |
| RNA 3 phosphate cyclase, RNA cyclase, RPC, RPC1, RTC1, RTCD1 | |
| RTCA, Rtcd1 | |
| IgG | |
| Antigen Affinity Chromatography | |
| Antibody |
Spot an opportunity for improvement?Share a Content Correction
Product Content Correction
Your input is important to us. Please complete this form to provide feedback related to the content on this product.
Product Title